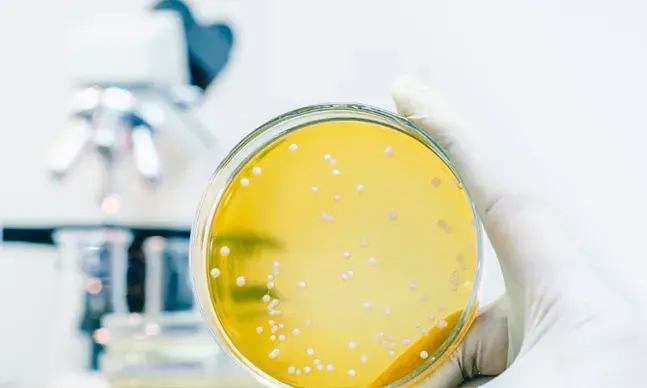
A Legionella pneumophila é uma bactéria que está presente na água e na terra, mas é quando se aloja nos nossos pulmões que se pode tornar mortal.

Hospital
- Hospital Lusíadas Beloura21 770 40 40geral@lusiadas.pt683482438.76499001,-9.36732768
- Clínica HeyDoc Campera21 154 74 71clinica.campera@heydoc.pt595913339.0282984,-8.96654152
- Hospital Lusíadas Maia22 012 44 33geral@lusiadas.pt569802841.25614468,-8.65366662
- Clínica HeyDoc Hospital Lusíadas Braga21 154 74 71clinica.hlbraga@heydoc.pt516958541.547433,-8.42243
- Clínica HeyDoc Paços de Ferreira21 154 74 71clinica.pacosferreira@heydoc.pt516958441.284459,-8.360726
- Clínica HeyDoc Hospital Lusíadas Porto21 154 74 71clinica.hlporto@heydoc.pt516958341.15738,-8.625954
- Clínica HeyDoc Clínica Lusíadas Almada21 154 74 71clinica.clalmada@heydoc.pt515588338.660081,-9.175387
- Clínica HeyDoc Hospital Lusíadas Amadora21 154 74 71clinica.hlamadora@heydoc.pt515588238.748693,-9.229635
- Clínica HeyDoc Clínica Lusíadas Oriente21 154 74 71515588138.79424,-9.103562
- Hospital Lusíadas Campera21 159 85 55geral@lusiadas.pt473812539.0282295,-8.9673602
- Hospital Lusíadas Paços de Ferreira25 507 34 00geral@lusiadas.pt460236641.284459,-8.360726
- Clínica HeyDoc Hospital Lusíadas Lisboa21 154 74 71clinica.hllisboa@heydoc.pt443587038.74965,-9.17951
- Clínica HeyDoc Vila Real21 154 74 71clinica.vilareal@heydoc.pt436080741.31154,-7.73345
- Clínica HeyDoc Minho Center21 154 74 71clinica.minhocenter@heydoc.pt436080641.5437,-8.40156
- Clínica HeyDoc Viana do Castelo21 154 74 71clinica.vianacastelo@heydoc.pt436080541.70459,-8.81468
- Clínica HeyDoc Gaia Shopping21 154 74 71clinica.gaiashopping@heydoc.pt436080341.11841,-8.61906
- Clínica HeyDoc São João da Madeira21 154 74 71clinica.sjmadeira@heydoc.pt436080240.89224,-8.49154
- Clínica HeyDoc Norte Shopping21 154 74 71clinica.norteshopping@heydoc.pt436080141.18093,-8.65463
- Clínica HeyDoc Guimarães Shopping21 154 74 71clinica.guimaraesshopping@heydoc.pt436080041.44081,-8.30432
- Clínica HeyDoc Almada21 154 74 71clinica.almada@heydoc.pt436079938.68007,-9.15711
- Clínica HeyDoc Telheiras21 154 74 71clinica.telheiras@heydoc.pt436079838.76533,-9.17423
- Clínica HeyDoc Cascais Shopping21 154 74 71clinica.cascaisshopping@heydoc.pt436079738.73829,-9.39803
- Clínica HeyDoc Leiria Shopping21 154 74 71clinica.leiriashopping@heydoc.pt432591839.73272,-8.82474
- Clínica HeyDoc Coimbra21 154 74 71clinica.coimbrashopping@heydoc.pt432591740.19443,-8.40909
- Clínica HeyDoc Santo António dos Cavaleiros21 154 74 71clinica.santoantoniocavaleiros@heydoc.pt432591538.81863,-9.17465
- Clínica HeyDoc Queluz21 154 74 71clinica.queluzpc@heydoc.pt432591438.75466,-9.25349
- Clínica HeyDoc Colombo21 154 74 71clinica.colombo@heydoc.pt432591338.75482,-9.18849
- Clínica HeyDoc Amadora21 154 74 71clinica.amadora@heydoc.pt432591238.44553,-9.13467
- Clínica HeyDoc Quinta do Marquês21 154 74 71clinica.quintamarques@heydoc.pt432591138.69684,-9.32636
- Clínica HeyDoc Oeiras Parque21 154 74 71clinica.oeirasparque@heydoc.pt432591038.70625,-9.30165
- MD Clínica Avenida de Roma21 154 74 71clinica.roma@heydoc.pt432590938.74464,-9.1395
- Clínica HeyDoc 5 de Outubro21 154 74 71clinica.5outubro@heydoc.pt432590838.73994,-9.14866
- Hospital Lusíadas Alfragide21 432 94 10geral@lusiadas.pt347667438.7422,-9.2308
- Hospital Lusíadas Santa Maria da Feira22 608 55 80geral@lusiadas.pt292394040.927189,-8.572576
- Hospital Lusíadas Vilamoura28 989 20 40geral@lusiadas.pt220883837.08085612,-8.11387725
- MD Clínica Amoreiras Plaza216 083 470clinica.amoreiras@heydoc.pt162465538.722792,-9.160851
- Hospital Lusíadas Porto22 605 64 50geral@lusiadas.pt571741.15738,-8.625954
- Clínica HeyDoc Forum Algarve21 154 74 71clinica.faro@heydoc.pt572737.028698,-7.945645
- Clínica Lusíadas Faro28 989 20 40geral@lusiadas.pt572637.019905,-7.929592
- Hospital Lusíadas Albufeira28 989 20 40geral@lusiadas.pt572537.1032,-8.2335
- Clínica Lusíadas Oriente21 499 93 80geral@lusiadas.pt572438.79424,-9.103562
- Hospital Lusíadas Amadora21 499 93 80geral@lusiadas.pt572338.748693,-9.229635
- Clínica Lusíadas Almada21 770 40 40geral@lusiadas.pt572238.660081,-9.175387
- Hospital Lusíadas Lisboa21 770 40 40geral@lusiadas.pt572038.748943,-9.176475
- Hospital Lusíadas Braga25 307 95 79geral@lusiadas.pt571941.547433,-8.42243
- Clínica Lusíadas Gaia22 605 64 50geral@lusiadas.pt571841.127049,-8.60574